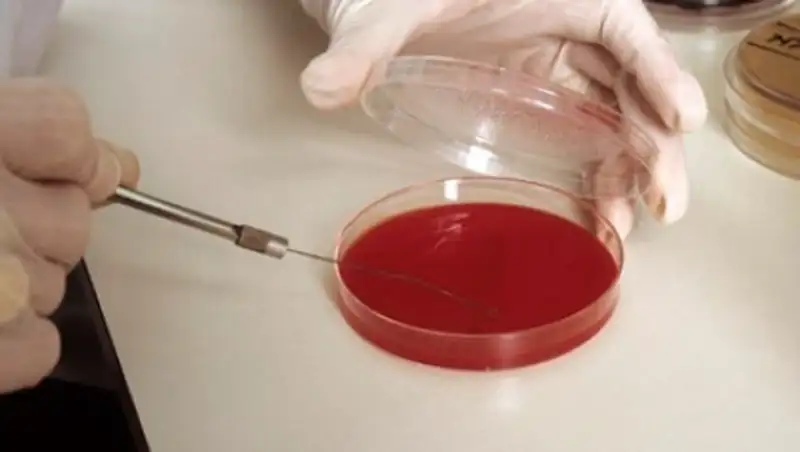

Ученые придумали способ побороть суперинфекции
Zakon.kz
Zakon.kz
Персонализированный подход в будущем станет основой медицины.
Иммунологи из Института наук де Гульбенкяна в Португалии разработали математическую модель, позволяющую использовать то лечение бактериальных инфекций, которое снижало бы риск формирования у бактерий устойчивости к антибиотикам и появления суперинфекций.
В модели также учитывается роль иммунной системы пациента. Результаты исследования опубликованы в журнале PLOS, пердает Лента.ру.
Антибиотики необходимы для лечения тяжелых бактериальных инфекций, однако их неправильное и чрезмерное использование приводит к формированию невосприимчивости микроорганизмов к лекарству. При наличии резистентности стандартные методы лечения становятся малоэффективными или не работают вообще. Поскольку новые антибиотики появляются довольно медленно, ученые стараются придумать методы эффективного использования имеющихся средств.
Исследователи создали математические основы для использования различных методов: агрессивного лечения с максимально возможной дозой антибиотика, умеренных методов терапии, которые комбинируют малые дозы препарата или более краткие сроки лечения, а также краткосрочной терапии. Моделирование и компьютерный анализ позволили сравнить эффективность процедур с фиксированной дозой, но с разной продолжительностью лечения, а также процедур, где как доза, так и продолжительность приема лекарств определяется состоянием пациента. По словам ученых, это также позволяет выяснить, как свести к минимуму риск развития резистентности.
Сильный иммунный ответ может стать основанием для снижения интенсивности лекарственной терапии, и модель позволяет предсказать, насколько. С учетом таких факторов, как сила иммунитета, доза антибиотиков, продолжительность лечения и сроки болезни, можно определить, будет ли соответствующее лечение успешным, или бактерии смогут развить устойчивость. Также модель помогает выяснить, вызван ли возможный рецидив чувствительными к антибиотикам микроорганизмами, а не резистентными, как это обычно предполагается.
Ученые утверждают, что подобный персонализированный подход в будущем станет основой медицины. Математические модели будут играть важную роль в получении клинически важной информации и разработке эффективных методов лечения.
Фото: Custom Medical Stock Photo / Globallookpress.com
Поделитесь новостью
Читайте также
Если вы видите данное сообщение, значит возникли проблемы с работой системы комментариев. Возможно у вас отключен JavaScript












